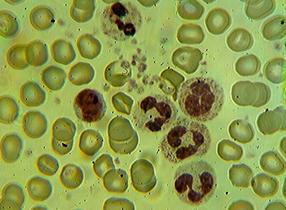

При использовании раствора №13 после размораживания через 30 суток хранения при –40°С количество Т - и В-лимфоцитов соответствовало их содержанию после 1 суток экспозиции при –40°С, а содержание растворенного в биосреде кислорода не изменялось по сравнению с уровнем нативных клеток (рис. 3.3.3.3).
 Рисунок 3.3.3.3 Содержание растворенного кислорода в лейкоцитных концентратах (ЛК; n=5) с криопротекторным раствором (КР) №13 до и после хранения при –40°С в течение 30 суток
Рисунок 3.3.3.3 Содержание растворенного кислорода в лейкоцитных концентратах (ЛК; n=5) с криопротекторным раствором (КР) №13 до и после хранения при –40°С в течение 30 суток
Применение хладоограждающего раствора №13, содержащего в исходной концентрации криопротектор ГМБТОЭМ - 30%, антигипоксант фумарат натрия - 2,8%, лимонную кислоту - 0,06 % и бидистиллированную воду до 100 мл позволяет сохранить лейкоциты в условиях умеренно-низкой температуры (–40°С) в течение 30 суток.
| Рисунок 3.3.1.1 Лейкоциты крови до воздействия отрицательной температуры
|
|
|
| Рисунок 3.3.2.1 Сегментоядерный нейтрофил с фагоцитированной микрочастицей латекса после 1 суток экспозиции при –40°С в хладоограждающем растворе №13
|
|
|
| Рисунок 3.3.3.1 Лейкоциты после 30 суток экспозиции при –40°С в хладоограждающем растворе №13
|
|
|
| Рисунок 3.3.3.2 Сегментоядерный нейтрофил с активными гранулами, содержащими катионные белки после 30 суток экспозиции при –40°С в хладоограждающем растворе №13
|
3.3.4 Определение интенсивности процесса перекисного окисления липидов и антиоксидантной активности методом индуцированной хемилюминесценции в лейкоцитных концентратах, перенесших воздействие температуры –40ºС в криоконсервирующем растворе №13 разной продолжительности
При изучении влияния каждого ингредиента хладоограждающих растворов №13, 16 и 18 на уровень ПОЛ-АОА лейкоцитов показано (табл. 3.3.4.1), что фумарат натрия (2,8%) не вызывает изменения уровня ПОЛ и АОА клеток. Криопротектор смешанного действия ГМБТОЭМ (30%) и криопротектор непроникающего действия ГЭК (7,5%) повышают (р<0,05) уровень ПОЛ и АОА, а криопротектор проникающего действия ПД (21%) снижает.
Таблица 3.3.4.1 Влияние ингредиентов хладоограждающих растворов №13, №16 и №18 на уровень ПОЛ и антиоксидантный потенциал ядросодержащих клеток крови (n=6, М±σ)
Исследуемый субстрат | Показатели хемилюминограммы | ||||
Imax | S | tg(-2α) | a | Z | |
ЛК | 115,0±26,6 | 843,8±142,9 | 26,2±5,54 | 0,25±0,02 | 7,5±0,5 |
+ ГМБТОЭМ 30% | 180,2±13,6 * | 1165,0±162,1 * | 44,2±4,5 * | 0,22±0,02 * | 6,5±0,5 * |
ЛК + ГЭК 5,7% | 166,2±17,4 * | 1127,0±76,1 * | 39,4±4,2 * | 0,23±0,01 * | 6,8±0,4 * |
ЛК + ПД 21% | 90,0±4,2 * | 675,2±18,5 * | 18,2±0,6 * | 0,27±0,01 * | 8,0±0,2 * |
ЛК + фумарат натрия 2,8% | 110,5±38,9 | 961,2±284,7 | 21,6±9,1 | 0,26±0,02 | 7,8±0,5 |
Примечания. ЛК – лейкоцитный концентрат. * - различие с величиной показателя лейкоцитных концентратов p<0,05.
При смешивании лейкоцитов с криоконсервирующим раствором №13 (табл. 3.3.4.2) уровень ПОЛ и АОА достоверно не изменяется.
Таблица 3.3.4.2 Показатели хемилюминограммы лейкоцитов (n=5, М±σ), перенесших воздействие умеренно-низкой температуры (–40°С) под защитой криоконсервирующего раствора №13 в течение 1 и 30 суток
Лейкоцитный концентрат | Показатели | ||||
Imax | S | tg(-2α) | a | Z | |
до замораживания | 77,2±11,9 | 590,8±50,6 | 17,7±3,3 | 0,25±0,02 | 7,7±0,8 |
до замораживания с раствором №13 | 94,0±21,6 | 674,0±99,0 | 20,4±5,7 | 0,24±0,02 | 7,2±0,7 |
через 1 сутки хранения | 120,5±26,9 | 699,2±105,2 | 32,1±8,2 * | 0,19±0,01 * | 5,8±0,5 * |
через 30 суток хранения | 101,5±12,1 | 669,5±51,6 | 24,7±3,8 | 0,22±0,02 | 6,6±0,5 |
Примечание. * - различие с величиной показателя до замораживания с хладоограждающим раствором p<0,05.
У клеток отогретых через 1 и 30 суток хранения при –40°С показатели ПОЛ соответствовали показателям до замораживания. Антиоксидантный потенциал лейкоцитов, хранившихся 1 сутки при –40°С достоверно увеличивался по сравнению с уровнем до замораживания. Показатели а, Z снижались, tg(-2α) возрастал, т. е. имеющийся у клеток антиоксидантный резерв был достаточен для стабилизации уровня ПОЛ. Однако через 30 суток экспозиции АОА клеток снижалась (р<0,05). Указанный срок был подтвержден ранее другими показателями жизнеспособности клеток (эозинорезистентность, фагоцитарная активность и др).
Хладоограждающий раствор №16 (табл. 3.3.4.3) не оказывает воздействия на повышение ПОЛ и АОА. У клеток хранившихся в данном растворе 1 сутки при –40°С указанные показатели соответствовали таковым до замораживания.
Таблица 3.3.4.3 Показатели хемилюминограммы лейкоцитов (n=6, М±σ), перенесших воздействие умеренно-низкой температуры (–40°С) под защитой криоконсервирующего раствора №16 в течение 1 суток
Лейкоцитный концентрат | Показатели | ||||
Imax | S | tg(-2α) | a | Z | |
до замораживания | 80,6±21,4 | 598,8±151,7 | 17,8±3,1 | 0,25±0,02 | 7,5±0,1 |
до замораживания с раствором №16 | 93,0±19,2 | 681,4±63,5 | 17,8±3,3 | 0,26±0,01 | 7,8±0,3 |
через 1 сутки хранения | 73,6±5,9 | 544,8±17,9 | 16,8±0,8 | 0,25±0,01 | 7,5±0,5 |
Примечание. Статистически значимых различий не выявлено.
3.4 Структурно-функциональные показатели лейкоцитов, перенесших воздействие низкой температуры (–80ºС)
3.4.1 Сохранность лейкоцитов, перенесших воздействие низкой температуры –80ºС без применения криозащитного раствора
Определение функциональных показателей лейкоцитов крови человека, подвергнутых воздействию низкой температуры –80°С без применения хладоограждающих сред, показало (М±σ; n=10), что в первые минуты после отогрева сохраняется 29,4±0,7% лейкоцитов от исходного уровня и их численность продолжает стремительно падать с увеличением времени экспозиции отогретых клеток при комнатной температуре. При этом мембраны клеток разрушены (эозинорезистентных лейкоцитов 0%), а в лейкоцитных окрашенных мазках отмечаются лишь «голые» лимфоидные ядра.
3.4.2 Структурно-функциональная сохранность лейкоцитов, перенесших воздействие низкой температуры –80ºС в течение 1 суток в криоконсервирующих растворах №19-24
На данном этапе исследования оценивали функциональные показатели лейкоцитов крови человека, подвергнутых воздействию отрицательной температуры –80°С в течение 1 суток в предложенных хладоограждающих растворах №19-24 (табл. 2.1) с целью выбора наиболее эффективного.
Установлено (табл. 3.4.2.1), что абсолютное и относительное число клеток после отогрева соответствует исходному уровню до замораживания только в опытах с раствором №20.
Количество клеток с непроницаемой для эозина мембраной после отогрева снижается при использовании всех вариантов хладоограждающих растворов, однако в меньшей степени это характерно для растворов №20, №22 и №23, под защитой которых сохраняется более 80% жизнеспособных клеток от исходного уровня.
Таблица 3.4.2.1 Показатели лейкоцитов (М±σ), перенесших воздействие низкой температуры (–80°С) в течение 1 суток в предложенных хладоограждающих растворах
Номер раст- вора | n | Показатели | ||
до замораживания | после отогрева | после отогрева в % от уровня до замораживания | ||
1 | 2 | 3 | 4 | 5 |
Количество лейкоцитов в 1 мкл | ||||
19 | 7 | 10180±4902 | 8250±4153 | 79,8±5,0+ |
20 | 7 | 12450±2191 | 12250±2472 | 96,8±4,1 |
21 | 7 | 17100±986 | 16192±1286 | 91,4±4,0+ |
22 | 11 | 16270±2320 | 14300±2549 | 93,7±3,9+ |
23 | 11 | 13020±2605 | 12180±2679 | 93,7±4,8+ |
24 | 11 | 16850±173 | 16000±983 | 96,2±3,8 |
Количество эозинорезистентных лейкоцитов в % | ||||
19 | 7 | 99,0±1,1 | 76,0±6,7* | 77,0±7,7+ |
20 | 7 | 97,5±0,5 | 86,2±7,6* | 88,6±7,3+ |
21 | 7 | 99,5±0,5 | 77,0±8,1* | 77,6±8,4+ |
22 | 11 | 97,1±1,9 | 79,6±8,7* | 82,3±10,6+ |
23 | 11 | 98,0±1,7 | 85,4±6,9* | 87,0±7,6+ |
24 | 11 | 94,3±3,6 | 56,7±10,1* | 60,2±10,4+ |
Количество гранулоцитов в % | ||||
19 | 7 | 17,0 ±2,2 | 14,6±3,6 | 82,8±13,4+ |
20 | 7 | 14,0±2,3 | 13,3±2,7 | 94,5±6,9 |
21 | 7 | 17,5±1,6 | 12,4±4,3* | 68,2±18,3+ |
22 | 11 | 27,3±5,2 | 6,7±2,5* | 24,0±5,6+ |
23 | 11 | 18,5±7,5 | 12,2±2,8* | 68,2±12,7+ |
24 | 11 | 19,2±10,7 | 4,9±4,2* | 24,11±9,2+ |
Количество фагоцитарноактивных нейтрофилов в % | ||||
19 | 7 | 51,0±1,1 | 28,2±3,3* | 55,0±7,2+ |
20 | 7 | 56,0±6,7 | 42,8±1,8* | 75,5±8,5+ |
21 | 7 | 44,0±1,1 | 25,2±1,5* | 57,0±4,0+ |
22 | 11 | 43,4±9,1 | 22,8±4,9* | 52,4±2,8+ |
Продолжение таблицы 3.4.2.1

|
Из за большого объема этот материал размещен на нескольких страницах:
1 2 3 4 5 6 7 8 9 10 11 12 13 14 15 16 17 18 19 20 21 22 23 24 25 26 27 |